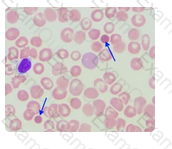

The primary mechanism responsible for glomerular filtration is:
Delayed hemolytic transfusion reactions (DHTR) usually occur within which time period?
Match each of the descriptions with the appropriate magnification:
1. Color, Rouleau, Overall Slide Quality, Cell Distribution
2. Platelet estimates RBC-platelet-WBC morphology WBC differential RBC inclusions
3. Select area to examine, WBC estimate
As a general rule, CSF glucose is about two thirds of the serum glucose measured in a normal adult.
Chemistry
Which of the following would be considered a normal cerebrospinal fluid glucose if the serum glucose is 70 mg/dl?
In the laboratory, surfaces must be disinfected for blood spills. What is the most common disinfectant used?
A regional laboratory that performs high volume, highly complex or infrequently ordered testing is a:
HLA-DR is a MHC class II(major histocompatibility complex) surface receptor on the cellular surface which is encoded by the human leukocyte antigen complex, or HLA.
DR antigens are found in which of the following systems:
Gram positive organisms resist decolorization by ethyl alcohol. The large crystal violet-iodine complex is not able to penetrate the peptidoglycan layer, and is trapped within the cell in gram-positive organisms. Conversely, the outer membrane of gram-negative organisms is degraded and the thinner peptidoglycan layer of gram-negative cells is unable to retain the crystal violet-iodine complex and the color is lost.
What is the purpose of using ethyl alcohol or acetone in the gram stain procedure:
Beer's law is based on the fact that absorbance is directly proportional to the concentration of a solution. Therefore, stray light can alter the absorbance results in this type of assay.
Deviations from Beer's Law are caused by:
The cells indicated by the arrows in the image are spherocytes. Spherocytes have a decreased surface to volume ratio and are therefore smaller with an increased MCHC. Spherocytes have lost their bi-concave shape and are spherical in shape, hence the name.
What are the cells that are indicated by the arrows in this peripheral blood smear image?
AABB Standards do not require a DAT, autologous control, or a minor crossmatch for pretransfusion testing.
Essential components of compatibility testing include all of the following except :
Estriol levels in conjunction with hCG and AFP can be obtained during pregnancy to:
During primary hypothyroidism, where a defect in the thryoid gland is producing low levels of T3 and T4, the TSH level is increased. TSH is released in elevated quantities in an attempt to stimulate the thryoid to produce more T3 and T4 as part of a feedback mechanism.
Serum TSH levels five-times the upper limit of normal in the presence of a low T4 and low T3 uptake could mean which of the following:
Antibodies are differentiated based on their heavy chains; different heavy chains create different isotypes. Humans have five different isotypes of immunoglobulins.
Immunology
The part of the molecule responsible for differences among immunoglobulin classes is:
Two CSF specimens were sent to the Lab with the following results:
Tube #1 = 11,200 rbc/µL
Tube #2 = 300 rbc/µL
The results on these CSF specimens are indicative of: